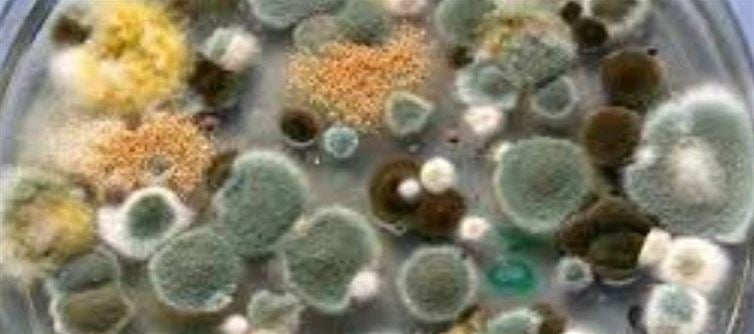

What is Aspergillus?
Aspergillus is recognized as a common group of fungi in many places of the world. It mainly affects the lungs and causes aspergillosis, which can be lethal. To track the future spread of Aspergillus, researchers employed a variety of modeling and forecasting tools. Scientists discovered during the study that certain varieties of Aspergillus will continue to grow as the climate issue worsens.
These species will spread to new regions of China, Russia, Europe, the United States, and Canada. According to one of the study's authors, Norman Van Rijn, researchers have focused more on viruses and parasites than fungi. According to him, these are anticipated to affect the world's key regions.
Why is this infection so deadly and who is at risk?
According to estimates, fungal diseases kill around 2.5 million people annually. Since not all data is available, the number might even be greater. Aspergillus, like many other fungi, is found in soils as microscopic filamentous filaments. They then produce a large number of spores that spread through the atmosphere. Humans breathe in these air contaminants daily. The majority of people often have no health problems since their immune systems are capable of handling the majority of dangers.
For those with COPD, cystic fibrosis, or asthma, that is different. Due to weakened immune systems, patients who have had organ transplants or cancer are particularly vulnerable. Van Rijn claims that the fungus grows if your immune system is unable to eliminate the spores. "The fungus starts to grow and basically kind of eat you from the inside out, saying it really bluntly," van Rijn stated.
If we continue to rely on fossil fuels, the range of Aspergillus flavus, which prefers hot and tropical environments, might increase by 16%, the study found. Candida species are still resistant to some medications and can produce very dangerous infections. Because of this, the illness can infect a variety of food crops, which makes it a major issue for food security as well.